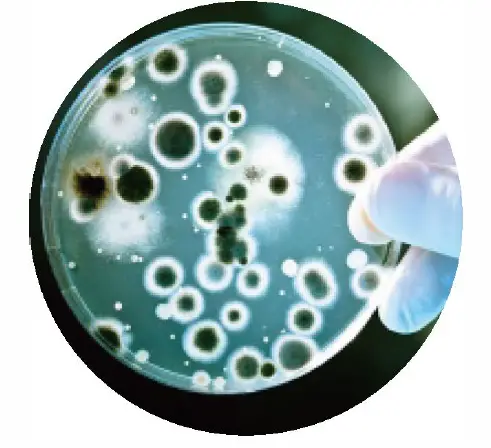
ALORAIR-Storm-SLGR-1600X-Dehumidifier-Owner-FIG-3

ALORAIR Storm SLGR 1600X Dehumidifier Owner

Distinct Features
- SLGRMicrochannel Technology
- Condensate pump
- Quick access to internal service
- More capacity, less power consumption
- Convenient storage for cable and drain tube
- Epoxy powder coating for corrosion protection
- Quick connector for Drain Tube and Cable
Two Main Damage of Flooding
Flood is an expensive natural disaster that does damage to multiple areas of human life, community, and industry. It includes damage to property, loss of human life, destruction of plants and crops, etc .. But to the restoration market, dehumidifier mainly focuses on the following two fields of restoration work. 
Structural damage
After flood sweeping house and farm, wooden structure house is susceptible to mold and rot. Wooden damage will lead to the uneven floor and deformed door frame, which exist high risks for a living. For exterior walls, it can easily absorb the moisture condensed on its cool surface. As the temperature of the wall continuously lowers, the wall absorbs more water. This is a terrible cycle as in the end the wall material will be absolutely damaged.
For high maintenance fee, 15% of the wooden parts request repair caused by rot and mold, which leads to about 20 billion board feet destruction of timber. That destruction is much more than what is destroyed by fire!
Health Condition Related To Waterborne Diseases
Excess dampness and moisture are the results of flooding. When relative humidity I evels reach 60% or higher in the space, it becomes the incubator for mold, mildew and fungi. Those microorganisms thrive on the surface of damp wood, dirt, cardboard and any kind of paper material.neuralgia, chronic bronchitis, cough, skin diseases like urticaria are all closely related to damp living environment people lives in. dampness-related factors are long, unconsciously and chronic damage to people’s inner health.
The Solution
Storm SLGR 1600X dehumidifier, as a professional dehumidifier for restoration marketing, has an amazing dehumidifying effect and restoration effect. It beats down conventional dehumidifiers absolutely with SLGRMicrochannel Technology adopted. Besides satisfactory restoration effect in normal humidity and temperature environment, Storm SLGR 1600X is a master-hand of the restoration field especially to dehumidify in hot dry environment and cold humid environment. 
SPECIFICATION
| Excellent In Low Humidity and High Temperature | |
| Power | |
| Size For | Up tp 4,000Sq.Ft |
| Filiter | MERV- 10 Filter |
| Air flow | 400 CFM |
| Sound Pressure Level | |
| Refrigerant | R410A |
| Wheel | 2 Samii Wheel |
| Draining Defrosting Control System | Condensate Pump Automatic Defrosting |
| Functioning Temperature Range | 33.8-110°F |
| Functioning Humidity Range | 25 – 80 % |
| Capacity115V (80 °F-60%) | 160 Pints/Day |
PROVEN PERFORMANCE
The Alorair 1600X brings the latest Alorair SLGR Technology to our Restoration Product line. Removing 160 PPD at AHAM and at
30″C/80% conditions, Storm SLGR 1600X is our newest SLGR dehumidifier. A Most powerful SLGR dehumidifier, Alorair has engineered high efficiency and high-temperature operation into one amazingly effective drying machine. even above 122 Degrees Fahrenheit. They are rugged yet mobile equipment that will operate under extreme
conditions and pull large amounts of moisture, offers extraordinary peformance in a variety range of jobsite conditions – in low humidity and high temperatures. As a water damage restoration professional, you need professional-grade equipment that helps you tackled the toughest of jobs and deliver outstanding results for your clients. A powerful SLGR dehumidifier is a key component in your suite of tools.


- The Front cover can be taken away without any interterence
- Main control board is in quick access design by releasing 4 Screws


How Does SLGR works?
SLGR microchannel technology has improved the performance and efficiency, The ALORAIR SLGR technology uses a special air-to-air heat exchanger system to help bring the air closer to dew point temperature before it passes over the super-cooled evaporator coils, besides with the combination of Microchannel Alu Condenser, Maximize the Capacity and efficiency. The purpose of a microchannel condenser is to improve energy efficiency. The use of microchannel condenser technology can improve the 50% dispersion effect of the condenser, 30% heat exchange area and 50% refrigerant quantity. When the SLGR microchannel is combined, the efficiency of the dehumidifier can be increased by 30-50%. This leads to more condensation that forms on the coils inside the machine, and fastest for an interchange of heat, which in turn leads to more moisture pumped out and less moisture in the air that is returned to the room. This extra efficiency makes ALORAIR SLGR dehumidifier perfectly suited for low humidity conditions.























